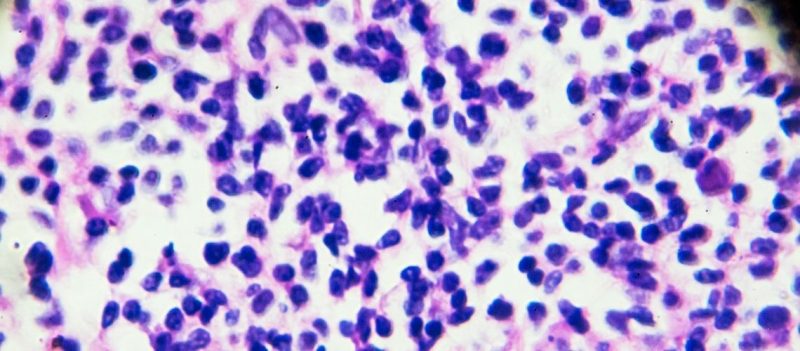
Mantle Hücreli Lenfoma: Nedir ve Nasıl Tedavi Edilir?
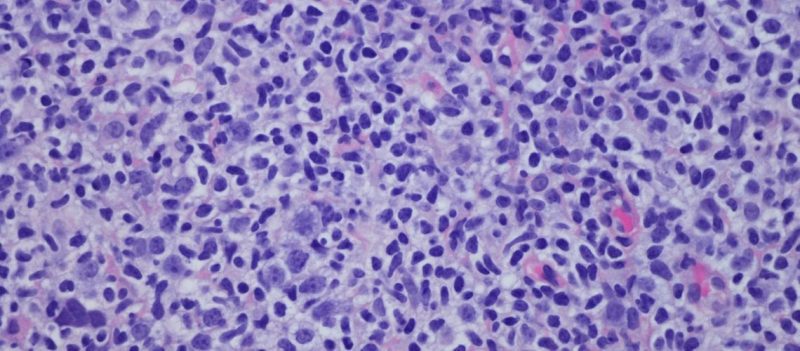
Hodgkin Lenfoma Döküntüsü Nasıl Görünür?

Akut Lenfoblastik Lösemi (ALL) Nedir? Belirtileri ve Tedavisi
Akut Lenfoblastik Lösemi (ALL), kanımızda ve kemik iliğimizde bulunan beyaz kan hücrelerinin (özellikle lenfosit adı [...]
Şub
Kronik Lenfositik Lösemi Nedir? Belirtileri ve Tedavisi
Kronik Lenfositik Lösemi (kısaca CLL), bağışıklık sistemimizin önemli bir parçası olan B lenfositlerinin (B hücrelerinin) [...]
Şub
Lenfoblastik Lenfoma (LL)
Lenfoblastik lenfoma (LL) nadir ve agresif bir non-Hodgkin lenfoma türüdür ve olgunlaşmamış B veya T [...]
Kas
Foliküler Lenfoma – Nedir, Belirtileri ve Tedavisi
Foliküler lenfoma (FL) B hücreli nazik Hodgkin lenfomaları içinde en sık rastlanan türlerden biridir ve [...]
Kas
Diffüz Büyük B-Hücreli Lenfoma
Diffüz Büyük B Hücreli Lenfoma (DLBCL) en sık görülen non-Hodgkin lenfoma alt türlerinden biridir ve [...]
Kas
Lenfoma (Lenf Kanseri) Tedavi Edilebilir Bir Hastalık mıdır?
Lenfoma bağışıklık sisteminin bir parçası olan lenf bezlerinde gelişen bir kanser türüdür ve tedavi edilebilme [...]
Kas
Lösemi ve Lenfoma Arasındaki Fark Nedir?
Lösemi ve lenfoma her ikisi de kan kanserleri grubuna girer; ancak kökenleri ve gelişim süreçleri [...]
Kas
Mantle Hücreli Lenfoma: Nedir ve Nasıl Tedavi Edilir?
Mantle hücreli lenfoma nadir görülen ve agresif bir non-Hodgkin lenfoma türüdür. Bu hastalık genellikle ileri [...]
Kas
Burkitt Lenfoması Nedir?
Burkitt lenfoması agresif seyir gösteren bir B-hücreli non-Hodgkin lenfoma türüdür. MYC geninde oluşan özel değişimlerle [...]
Kas
Hodgkin Lenfoma Döküntüsü Nasıl Görünür?
Hodgkin lenfoması genellikle cilt üzerinde belirgin döküntüler oluşturmasa da bazı durumlarda deri üzerinde çeşitli lezyonlara [...]
Kas